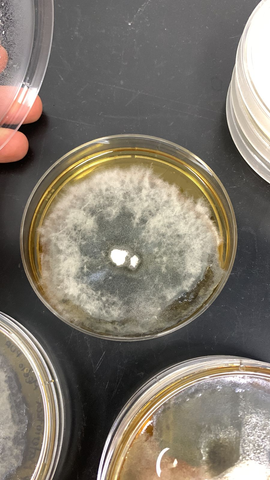
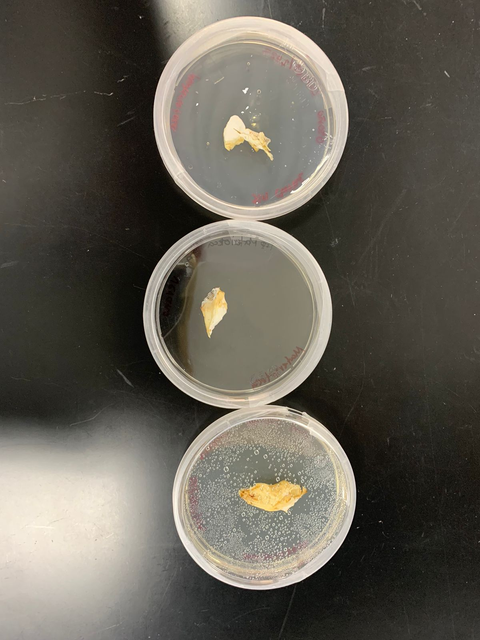

"Crafting sustainable futures through mindful design thinking
and user-centric innovation."
-Sarah Rivera


Who am I? and what I do?
Hello, I'm Sarah Rivera.
I am a Strategic Product Designer, which makes me a
designer knowledgeable in various tools, allowing for more comprehensive and complete projects with a panoramic perspective.
Currently, I work on social products & projects that aim for social awareness, utilizing circular and sustainable design approaches.

Industrial &
Product Design
I integrate branding and marketing strategies into my product design projects, aiming to address social causes or specific needs. Emphasizing longevity over disposability, my approach involves strategic thinking to extend a product's life cycle. By redefining the product's end-of-life stage, I consider user interaction and manipulation, fostering a more sustainable approach
to product design.
Concept &
Circular Design
Most of my product design projects involve integrating branding and marketing strategies aiming to address social causes or specific needs. It's crucial to avoid creating disposable products, instead focusing on extending a product's lifespan through strategic thinking. This involves redefining the product's end-of-life stage by considering the user's interaction and manipulation for a sustainable product lifecycle.
... and More
Beyond crafting products, I derive equal fulfillment from showcasing them digitally. Engaging in 3D design for animations and art-directed campaigns complements my industrial design work. These diverse facets intertwine, enriching my creative endeavors across fashion and industrial design, enriching my work across fashion and industrial design realms, amplifying
my creative pursuit.
Showcased projects
Plubio
Marice collection
Kaleidoscopio Footware collection
GreenTech, Green Utopia campaign
Bóveda Celeste
Franns, Life cycle analysis
Rure ecokit package
Kokon
Mycellium seedbed
p. 7
p. 13
p. 19
p. 26
p. 31
p. 38
p. 44
p. 49
p. 56

Industrial & Concept Design
Ideation Process

Problem Statement:
62% of the inhabitants in Guadalajara, Mexico, live in areas with scarce green spaces; two out of three residents fall short of the perimeter recommended by the WHO. Additionally, 34% of the population lives in critical areas or severely lacking spaces, with less than 4m² of green areas. Additionally, according to the report 'Water in Mexico', 12 million people lack access to drinking water. Simultaneously, droughts have intensified over the last decade, and aquifer overexploitation has increased by 15 percent.
Our proposal solves:
Because Guadalajara, Mexico, is one of the states with the highest rainfall, being the wettest season lasts 3.7 months, from June 8th to September 30th, with over a 40% probability of a day being wet. We decided to create 7622m2 green adobe walls housing endemic plants, placed in parks and avenues across the city, featuring a rainwater harvesting system that stores up to 2,500 liters. This tank can be filled approximately 13 times per year and stored in free water fountains, leading to an average saving of 4,000 pesos annually in water access costs, equivalent to roughly one month of their family income.


Sarah Rivera
+34 608 876 871
riverasanchez.sarah@gmail.com
Page 8
Industrial & Concept Design
Product Overview







Sarah Rivera
+34 608 876 871
riverasanchez.sarah@gmail.com
Page 9
Industrial & Concept Design
Product Overview




Drinking water fountain
supplied by the water storage
Rainwater collection system
with filtration and purification
Pots for plants made with
recycled plastic through
plastic injection
Water filtration and
retention system
for plant irrigation
Mesh that allows
water filtration
Fertilized soil with
rainwater for the
preservation of
endemic plants
in Guadalajara
Adobe wall
for plant proliferation
Page 10
Sarah Rivera
+34 608 876 871
riverasanchez.sarah@gmail.com
Industrial & Concept Design
Gallery & Usage





Sarah Rivera
+34 608 876 871
riverasanchez.sarah@gmail.com



Page 11


Marice
Leather goods
Industrial & Concept Design
Ideation Process
Problem Statement
The fashion industry's extensive manufacturing practices have precipitated environmental deterioration, marked by excessive waste production, water contamination, and heightened carbon emissions. Concurrently, the pervasive existence of unregulated, underpaid labor in this sector exacerbates societal disparities and jeopardizes the welfare of workers.
Our proposal solves:
To address these concerns, our endeavor introduces a vegan leather goods brand emphasizing modularity, to prolonging product lifespan and enhancing quality. This innovative approach facilitates two-in-one items, fostering sustainability and reducing waste. By prioritizing versatility and durability, we strive to counter the fashion industry's disposability culture, promote eco-consciousness, and endorse a more responsible consumer mindset.
Additionally, our brand exhibits a profound commitment to environmental stewardship. 20% of our brand's revenue will be allocated to conservation associations focused on animal welfare, alongside a campaign aimed at fostering community engagement in marine and beach cleaning efforts. Furthermore, our use of recycled materials and leathers champions the design and innovation of biomaterials and sustainable resources, furthering our dedication to eco-friendly practices and materials.
Sarah Rivera
+34 608 876 871
riverasanchez.sarah@gmail.com
Marice
@sarahooy.brand


Page 14
Industrial & Concept Design
Marice
Eco packaging
Product Overview
@sarahooy.brand

Eco labels
Reusable bag

"Kraft Paper Bag
with eco-friendly
gold ink, and leather tag


Tags with eyelets and
ribbon in eco-friendly
gold ink made from
kraft paper
Repair Kit
Included Repair Kit with Every Purchase: Comes with skin cream, leather oil, suede restorer, and fabric lining repairer (to extend the product's lifespan and raise user awareness)
Sarah Rivera
+34 608 876 871
riverasanchez.sarah@gmail.com
Page15


Industrial & Concept Design
Product Overview
Video studio
Modular-
Transformable Dress
Sarah Rivera
+34 608 876 871
riverasanchez.sarah@gmail.com
Marice
@sarahooy.brand
Page 16
Industrial & Concept Design
Marice
Collection

Wallet/Cardholder
Gallery & Usage
@sarahooy.brand



Converter shoulder bag
to crossbody bag

Tote Bag Convertible
into a Backpack
Expandable purse with
add on crossbody strap
Page 17
Sarah Rivera
+34 608 876 871
riverasanchez.sarah@gmail.com
Weekender bag
with Zip-On, Zip-Off
Lower Compartment


Slow fashion footwear
Industrial & Concept Design
Ideation Process
Problem Statement
The fashion industry's mass production has led to environmental degradation, including excessive waste generation, water pollution, and carbon emissions. Further to this, the prevalence of unregulated, underpaid jobs in this sector perpetuates social inequalities and compromises the well-being of workers. In Mexico specifically, the textile industry is one of the country's largest sources of industrial pollution, ranking among the top contributors to water contamination. Approximately 20% of the industrial water pollution in Mexico results from textile dyeing and treatment processes, severely impacting water quality and aquatic ecosystems.
Our proposal solves:
Our initiative aims to counter these issues by introducing a startup dedicated to crafting handmade, slow fashion shoes introducing our base shoes in a colecction of four pieces. This artisanal approach ensures meticulous attention to detail, using sustainable materials, and promoting ethical production practices. By embracing slow fashion, we prioritize quality over quantity, mitigate environmental impact, and provide fair wages while celebrating craftsmanship and individuality in every pair of shoes produced. Initiatives promoting slow fashion, such as the incorporation of handmade, artisanal approaches, hold the potential to significantly reduce environmental impact while fostering fair wages and dignified working conditions for employees.
Sarah Rivera
+34 608 876 871
riverasanchez.sarah@gmail.com



Page 20



Industrial & Concept Design
Product Overview


3/4 view


Back view

Upper view
Left side
Bottom view








Page 21
Sarah Rivera
+34 608 876 871
riverasanchez.sarah@gmail.com

Industrial & Concept Design
Product Overview
Shoelaces
Upper
Insole
Straps
Lining
Synthetic flower shaped cut outs

Sarah Rivera
+34 608 876 871
riverasanchez.sarah@gmail.com





Left view
Upper view
Back view
3/4 view

Bottom view
Page 22
Industrial & Concept Design
Gallery & Usage



Sarah Rivera
+34 608 876 871
riverasanchez.sarah@gmail.com










Page 23

"Cultivating Sustainability via Design Campaigns: Inspiring Innovation
and Change."

Industrial & Concept Design
Ideation Process
Problem Statement
The urgency of addressing the climate crisis and transitioning towards a comprehensive circular economy demands a mindset shift towards utopian thinking. Innovative visions and bold communication are essential to surpass the pace of climate change. As emphasized by Bernhard Puttinger, Managing Director of the Green Tech Valley Cluster, the need for rapid, green solutions necessitates visionary approaches. Green Tech Valley stands as a crucial international hub for green research and innovation, highlighting the significance of fostering these innovative ideas and promoting them through effective communication strategies.
Our proposal solves:
To address this, a collaborative campaign involving visual and communication designers, architects, and biotechnologists at the universities of Graz, where I'm actively involved during my exchange program, seeks to inspire researchers and raise public awareness to support green companies.
Buildings, presently viewed as contributors to climate challenges, contain high levels of CO2 emissions in materials like concrete and bricks. Over 10% of Austria's greenhouse gas emissions stem from construction. The vision of "Building as CO2 storage" transforms structures into carbon sinks, storing more CO2 than emitted in production, achieving a climate-positive status. Timber, when sustainably managed, retains carbon, a vital lever.
Sarah Rivera
+34 608 876 871
riverasanchez.sarah@gmail.com



Page 27
Industrial & Concept Design
Product Overview








Sarah Rivera
+34 608 876 871
riverasanchez.sarah@gmail.com



Page 28
Industrial & Concept Design
Gallery & Usage




Sarah Rivera
+34 608 876 871
riverasanchez.sarah@gmail.com
Page 29


Industrial & Concept Design
Ideation Process
Problem Statement
During the pandemic, we experienced a lot of crises as we couldn't leave our homes, had to isolate ourselves, and crowded places had to minimize the number of people. Additionally, many started to suffer from stress and anxiety. We were developing an unhealthy obsession with technology, which, in a positive sense, helped us continue our societal activities. However, we needed to learn to use it wisely, avoiding additional stress.
Our proposal solves:
The creation of a restauranted called Boveda Celeste. Our main concept was that it had a greenhouse integrated to harvest their own fruits and vegetables, making it a sustainable restaurant. We wanted to convey this to our customers, adhering to health regulations. That's why our main restaurant space consisted of tables lined with herbs from our harvest, alongside lavender and stress-reducing plants. The tables featured a self-service and self-checkout system by card to minimize contact. Also, high-performance charging stations were implemented to create a safe workspace, offering a different environment outside the home where people could enjoy a meal while following health guidelines.
Sarah Rivera
+34 608 876 871
riverasanchez.sarah@gmail.com



Page 32
Industrial & Concept Design
Product Overview
Restaurant concept and Architectural plans






Sarah Rivera
+34 608 876 871
riverasanchez.sarah@gmail.com
Page 33
Industrial & Concept Design
Product Overview
Design Criteria
Use of technology
Environmental care-oriented
Aids in social distancing
Improves mood and reduces stress
Incorporation of plants
Functions
Movable
Self-checkout interface
Self-service interface
Personal workspace
Electricity connections
Sarah Rivera
+34 608 876 871
riverasanchez.sarah@gmail.com
Table industrial design





Page 34
Industrial & Concept Design
Gallery & Usage









Sarah Rivera
+34 608 876 871
riverasanchez.sarah@gmail.com
Page 35


"As a designer, my role extends beyond creating new products; it involves considering their lifecycle impact and raising user awareness and educating about their carbon footprint."

Industrial & Concept Design
Life cycle analysis
Problem Statement
Production lines that disregard environmental considerations pose several significant problems. They often lead to excessive resource consumption, energy inefficiencies, heightened emissions, and substantial waste generation throughout the manufacturing process. The lack of emphasis on a circular design and economy exacerbates these issues, perpetuating a linear "take-make-dispose" model. This linear approach fails to account for the environmental impacts of a product's entire life cycle, from raw material extraction to disposal, causing long-term harm to the environment.
Our proposal solves:
A life cycle analysis of a product with the company FRANNS with solutions to raise awareness of the impacts of mining in Mexico and there propose solutions that include other processes, materials and other types of circular economies to reduce impacts on the environment atmosphere.
That way:
- Understand and identify the stages that generate a greater impact.
- Address the points of greatest impact to generate a circular design proposal, to improve the jewelry production process.
Sarah Rivera
+34 608 876 871
riverasanchez.sarah@gmail.com



Page 39
Industrial & Concept Design
Life cycle analysis

The diagram shows that the production phase has the most significant environmental impact, particularly concerning silver, accounting for 58.1% and emitting 5.18 kg CO2 eq. during welding, as well as 56.3% related to silver rods, equivalent to 5.02 kg CO2 eq.


Sarah Rivera
+34 608 876 871
riverasanchez.sarah@gmail.com


Page 40
Industrial & Concept Design
Life cycle analysis results

It can be noted that the greatest impact of a pendant occurs during the production stage and to a lesser extent in the procurement of raw materials. The other processes do not represent much in the graphic, and the remaining small percentage accounts for its use.


Sarah Rivera
+34 608 876 871
riverasanchez.sarah@gmail.com

To conclude and comprehend the impact of a necklace and a pendant, along with the overall jewelry and metallurgy process, we'll compare the CO2 emissions throughout the product's lifecycle, from extraction, production, usage, and maintenance to transportation and packaging, in relation to everyday items used today. We'll also consider the number of trees required to offset these CO2 emissions and identify potential areas for improvement.

Page 41
Industrial & Concept Design
Awareness, proposals and resolutions
Recycling and Self-care Campaign






This would ensure that:
- Fair and circular trade practices are established concerning payment.
- Effective information dissemination and environmental communication are achieved indirectly.
- Proper use and maintenance are encouraged, minimizing the overall impact.
Sarah Rivera
+34 608 876 871
riverasanchez.sarah@gmail.com

Creation of a new packaging

Change in production: Recollection of
Recycled Silver and Creation personalized molds


This would ensure that:
- The end-of-life of the piece is collected by the same company and can be traced in the future.
- The lifespan of the jewelry pieces can be extended, reducing the frequency and necessity of maintenance (due to proper care and preservation).
- No waste or unnecessary expenses are generated.
This would ensure that:
- The increased production in obtaining silver is counteracted by the recycling of silver, thereby reducing its impact.
- We become self-sustaining and generate fewer silver consumables.
- Raising user awareness regarding metallurgy recycling; although silver is a durable material, its impact can be substantial.
Page 42



Industrial & Concept Design
Ideation Process
Problem Statement
Packaging design often contributes to environmental issues, as it tends to generate significant waste. Conventional packaging materials, particularly those used for retail products, contribute substantially to landfill waste and pollution. This often contradicts the concept of sustainable products, deterring eco-conscious consumers from purchasing these items due to the excessive packaging waste generated.
Our proposal solves:
Our solution involves innovative packaging design for a zero-waste eco kit that aligns with the sustainable values of the product it contains. By implementing compostable packaging materials, we aim to create a packaging solution that mirrors the zero-waste philosophy of the eco kit. The use of compostable packaging not only encourages consumers to buy the eco-friendly kit but also ensures that the packaging itself can be disposed of sustainably, reducing landfill waste and promoting environmentally friendly consumption.
Sarah Rivera
+34 608 876 871
riverasanchez.sarah@gmail.com



Page 45
Industrial & Concept Design
Product Overview



Sarah Rivera
+34 608 876 871
riverasanchez.sarah@gmail.com
Page 46
Industrial & Concept Design
Gallery & Usage






Sarah Rivera
+34 608 876 871
riverasanchez.sarah@gmail.com
Page 47


Industrial & Concept Design
Ideation Process





Sarah Rivera
+34 608 876 871
riverasanchez.sarah@gmail.com
Page 50
Industrial & Concept Design
Product Overview



Sarah Rivera
+34 608 876 871
riverasanchez.sarah@gmail.com
Page 51


Industrial & Concept Design
Product Overview















Page 52
Sarah Rivera
+34 608 876 871
riverasanchez.sarah@gmail.com
Industrial & Concept Design
Product Overview







Sarah Rivera
+34 608 876 871
riverasanchez.sarah@gmail.com





Page 53
Industrial & Concept Design
Gallery & Usage





Sarah Rivera
+34 608 876 871
riverasanchez.sarah@gmail.com
Page 54




Industrial & Concept Design
Ideation Process
Problem Statement
Existing carbon source-based products contribute significantly to environmental degradation and resource depletion. Our exploration into regenerative agriculture practices in Jalisco, Mexico, unveils the potential of mycelium-based biomaterials as an eco-friendly alternative. These biomaterials, replacing conventional plastics, offer a path to supporting regenerative agriculture. By reducing carbon emissions, enhancing food security, and bolstering natural ecosystems, they present a viable solution to the environmental challenges posed by traditional carbon-based products.
Our proposal solves:
Our research delves into regenerative agriculture practices in Jalisco, Mexico, seeing it as a key source for biomaterial production. Envisioning a future with 'truly regenerative materials,' we explore how biomaterials replacing plastics can support regenerative agriculture by reducing carbon, ensuring food security, and strengthening natural ecosystems. Our product is a 3D mold for cultivating mycelium seedbeds, containing auxins, plant hormones enhancing growth and that are biodegradable and support the soil as fertilizer. This fortified the plant, reducing susceptibility to diseases caused by parasites or bacteria. It justifies the added value of the mycelium's price, offering a biodegradable solution that integrates naturally into the soil, fortifying the plant—a systemic design approach.
Sarah Rivera
+34 608 876 871
riverasanchez.sarah@gmail.com



Page 57
Industrial & Concept Design
Ideation Process
Fieldwork with farmers to
Define primary and secondary users and plant types


Wood
Plants

Agriculture & harvest food plants

Houseplants

Large-scale
producers

Local farmers
& producers

Household
users
Why corn and bean
plants in Jalisco

JALISCO
Produces annually 3,087,917 tons of corn
88%
Represents its contribution to the national grain production
1° Place
7° Place
Producer of grain and forage corn, agave, grasses, and sugarcane, agave, grasses, and sugarcane
México ranks as the 7th largest producer of this grain globally
Sarah Rivera
+34 608 876 871
riverasanchez.sarah@gmail.com
Page 58
Industrial & Concept Design
Product Overview
SolidWorks BLUEPRINTS and views








Sarah Rivera
+34 608 876 871
riverasanchez.sarah@gmail.com
MDF ROUTER MYCELIUM PLATES


3D PRINT MOLD
SEEDBEED 2 SLOTS




MDF ROUTER MOLDS
SEEDBEED 4 SLOTS
Page 59
Industrial & Concept Design
Product Overview
GANODERMA AUTONOMA - ITESO

Ganoderma ITESO
Contamination
Ganoderma ITESO
Ganoderma Autónoma
successful insulation Ganoderma ITESO

1
2
3
4

SUBSTRATE MYCELIUM PRODUCTION


100%
100%
=
100%
=
=

Sample 3

sample 1

Sample 2



Coffee grounds
Sawdust
wood shavings
Sarah Rivera
+34 608 876 871
riverasanchez.sarah@gmail.com
MYCELIUM PRODUCTION AND MOLDS IN LABORATORY




Page 60
Industrial & Concept Design
Gallery & Usage

3D print y MDF Router molds to grow mycelium



Sarah Rivera
+34 608 876 871
riverasanchez.sarah@gmail.com

Mycelium grown seedbeds



Page 61

My vision and my mision
As a designer, my passion lies in strategic and holistic design, highlighting innovative and visionary projects that address current and future challenges. My vision is to merge innovation with strategic design to propel products that are not only aesthetically appealing but also address social, environmental, and technological issues. My mission is to create functional and sustainable solutions by incorporating user-centered design practices, integrating cutting-edge technology, and adopting holistic approaches for each project. When working with clients, I aspire to collaborate closely, understanding their needs and goals to deliver meaningful designs that make an impact and promote positive change in society.
- Sarah Rivera
Strategic Designer
Contact
Email:
riverasanchez.sarah@gmail.com
Phone number:
+34 603 876 871
+52 (33) 1017 6684
Follow me on social media:


@Sarahooy

